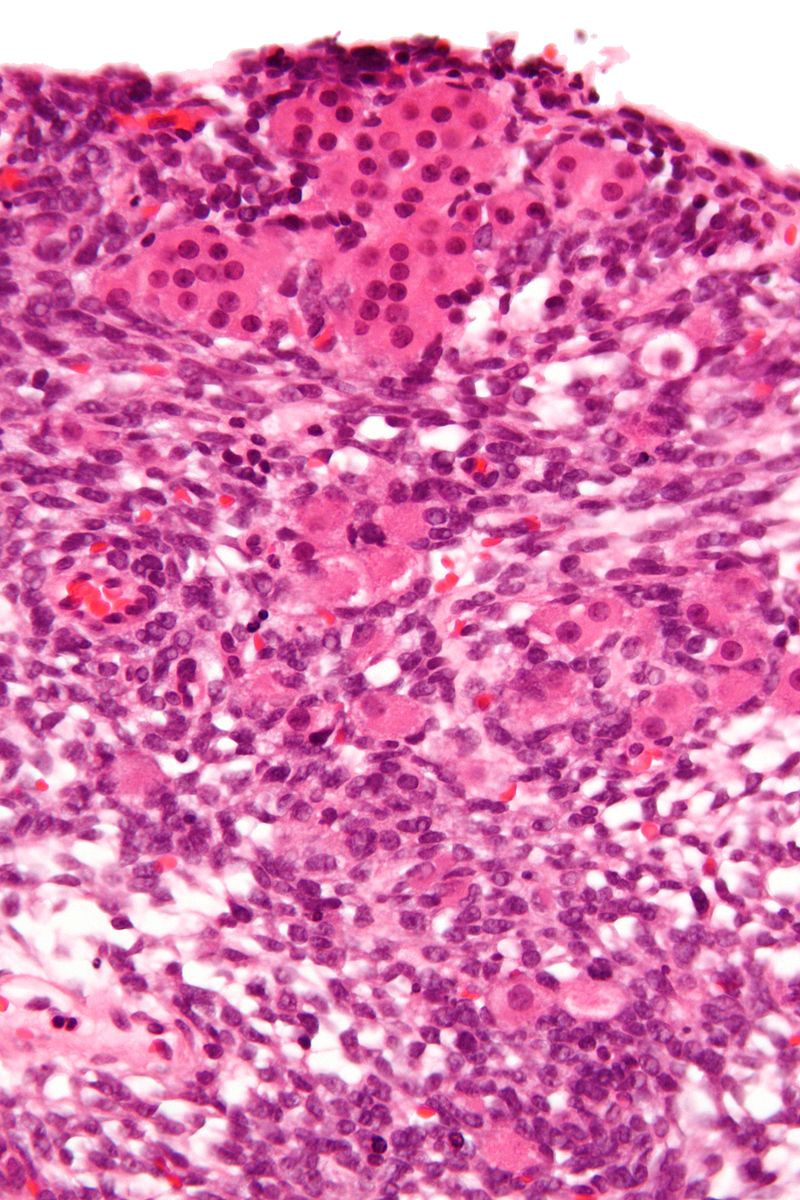
Sertoli-Leydig Cell Tumor

Ovary
The follicle is the ovary’s functional unit.
An oocyte and granulosa and theca cells surround the oocyte in a follicle.
The luteinizing hormone or (LH) stimulates theca cells to produce androgen.
The follicle-stimulating hormone (FSH) stimulates granulosa cells to convert androgen to estradiol, which drives the endometrial cycle’s proliferative phase.
A luteinizing hormone (LH) spike brought on by an estradiol surge causes ovulation, which marks the start of the secretory phase of the endometrial cycle.
The follicle that remains after ovulation develops into a corpus luteum, which predominantly secretes progesterone to stimulate the secretory phase and get the endometrium ready for a potential pregnancy.
Particularly in the early stages of pregnancy, bleeding into the corpus luteum can cause a hemorrhagic corpus luteal cyst.
Follicular cysts are the outcome of follicle degeneration.
Follicular cysts in small numbers are typical in women and have no clinical relevance.
Polycystic Ovarian Syndrome (PCOS)
Polycystic ovarian syndrome (PCOS) may result from obesity, stress, and hormonal imbalance, the ovaries generate an excessive number of immature or partially mature eggs.
About 5% of women of reproductive age experience polycystic ovarian syndrome.
Lab values in polycystic ovarian syndrome (PCOS) show:
- Elevated androgens
- Elevated luteinizing hormone (LH)
- Decreased follicle stimulating hormone (FSH)
Hirsutism, or extra hair in a male distribution, is caused by an increased luteinizing hormone (LH) inducing excessive androgen production from theca cells.
Then, in adipose tissue, androgen is transformed into estrone.
High levels of circulating estrogen raise the risk for endometrial cancer while estrogen feedback decreases follicle stimulating hormone (FSH), which results in cystic follicle degeneration.
A young woman with obesity, oligomenorrhea, and hirsutism makes a classic presentation for polycystic ovarian syndrome.
Ovarian Tumors
The ovary is composed of three cell types:
- Surface epithelium
- Germ cells
- Sex cord-stroma
Tumors can arise from any of these cell types or from metastases.
Surface Epithelial Tumors
About 70% of ovarian tumor cases are surface epithelial tumors, which are the most common type.
Surface epithelial tumors are derived from the ovarian coelomic epithelium.
The endometrium, endocervix or mucinous cells, and serous cells that make up the fallopian tube’s epithelial lining are all produced by coelomic epithelium embryologically.
Serous and mucinous surface epithelial tumor subtypes are the two most prevalent types.
Both serous and mucinous epithelial tumors are usually cystic.
Mucinous tumors are filled with mucus.
Serous tumors are filled with watery fluid.
Mucinous and serous tumors can both be benign, precancerous, or malignant.
Cystadenomas are benign tumors that are made up of a single cyst with a simple, flat lining and most frequently develop in premenopausal women between the ages of 30 and 40-years-old.
Contrarily, malignant tumors (cystadenocarcinomas), are made up of complex cysts with a thick, shaggy lining, most commonly develops in postmenopausal women between the ages of 60 and 70-years-old.
Tumors that are borderline have characteristics that fall between benign and malignant.
Borderline tumors have a better prognosis than tumors that are obviously malignant, but they still have the ability to spread.
BRCA1 mutation carriers have an elevated risk for serous carcinoma of the ovary and fallopian tube, and because of the higher risk for breast cancer, they frequently choose to have both a prophylactic salpingo-oophorectomy and a prophylactic mastectomy.
Less common subtypes of surface epithelial tumors include endometrioid and Brenner tumor.
Endometrioid tumors, which contain glands that resemble endometrial tissue, are typically cancerous.
Endometrioid tumors might be caused by endometriosis.
An independent endometrial carcinoma or the endometrioid type is linked to 15% of endometrioid carcinomas of the ovary.
Brenner tumors are typically benign and consist of bladder-like epithelium.
Clinically, surface tumors usually appear years later with unusual abdominal symptoms including discomfort and fullness or compression symptoms like frequent urination.
Surface epithelial carcinoma is thought to have the worst prognosis of all female genital tract tumors due to its generally poor prognosis.
Localized epithelial cancers often spread, particularly to the peritoneum.
The serum marker CA-125 can be used to check for recurrence and track therapy effectiveness.
Germ Cell Tumors
Germ cell tumors are the second-most common kind of ovarian tumor (~15%).
Germ cell tumors typically affect females who are fertile.
Germ cell tumor subtypes mimic tissues normally produced by germ cells.
Fetal tissue is a cystic teratoma and embryonal carcinoma oocytes-dysgerminoma.
Yolk sac endodermal sinus tumor.
Placental tissue choriocarcinoma.
Teratoma
A teratoma is a cystic tumor made of tissue from two or three embryological layers, including the stomach, thyroid, skin, hair, bone, and cartilage.
Struma ovarii is a teratoma composed primarily of thyroid tissue.
Dysgerminoma
Dysgerminoma is the most common malignant germ cell tumor that is made up of big cells with oocyte-like central nuclei and transparent cytoplasm.
Lab values of dysgerminoma show:
- Serum lactate dehydrogenase (LDH) may be elevated
- Serum alpha-fetoprotein (AFP) is often elevated
Dysgerminoma is treated with radiotherapy.
The prognosis of dysgerminoma is good if radiotherapy treatment is initiated.
Choriocarcinoma
Trophoblasts and syncytiotrophoblasts make up the malignant tumor known as choriocarcinoma.
Choriocarcinoma mimics placental tissue, however, villi cannot be found here.
Choriocarcinoma are described as being small, hemorrhagic tumors that move through the bloodstream quickly.
Choriocarcinoma have poor responses to chemotherapy.
Embryonal Carcinoma
Embryonal carcinoma is a malignant tumor made up of massive, aggressive primordial cells that metastasize quickly.
Sex Cord Stromal Tumors
Sex cord stromal tumors are ovarian tumors that resemble sex cord-stromal tissues.
A tumor composed of granulosa and theca cells is known as a granulosa-theca cell proliferative tumor.
Sex cord stromal tumors often release estrogen and exhibit indications of excess estrogen.
Precocious puberty may be an indication to check a child for sex cord stromal tumors.
Postmenopause is the most common setting for granulosa-theca cell tumors which may present as endometrial hyperplasia with postmenopausal uterine bleeding.
Sertoli-Leydig Cell Tumor
Sertoli cells form tubules in the Sertoli-Leydig cell tumor, which also contains Leydig cells between the tubules and distinctive Reinke crystals.
Sertoli-Leydig cell tumor may generate androgen, which is linked to both virilization, in which females exhibit traits associated with male hormones, and hirsutism, or excess hair in a male distribution.
Fibroma
A fibroma, often called a uterine fibroid, is a benign tumor that frequently develops in the uterus’ smooth muscle layer.
Fibromas are a benign fibroblastic tumor.
Fibromas are characterized by pleural effusions and ascites, which are features of the Meigs syndrome, a condition that is treated by removing the tumor.
Krukenberg Tumor
The most common cause of the metastatic mucinous Krukenberg tumor, which affects both ovaries, is metastatic gastric carcinoma (diffuse type).
Mucinous Carcinoma
Mucinous carcinoma is a primary mucinous carcinoma of the ovary.
Bilaterality helps distinguish metastases from primary mucinous carcinoma of the ovary (primary mucinous carcinoma is usually unilateral).
Pseudomyxoma Peritonei
Massive amounts of mucus in the peritoneum are a symptom of pseudomyxoma peritonei.
Appendiceal mucinous tumor that metastasize to the ovary frequently cause pseudomyxoma peritonei.